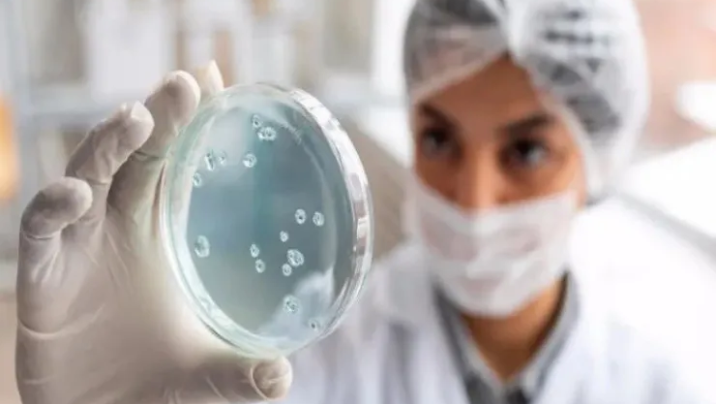

Hazırda ölkə ərazisində bu xəstəliklə bağlı insanlar arasında yoluxma faktı aşkarlanmayıb.
Stopnarkotik.az xəbər verir ki, bu barədə Səhiyyə Nazirliyi açıqlama yayıb.
Bildirilib ki, sosial şəbəkələrdə "Anadolu Universitetinin Bakı filialında təhsil alan Elnarə Həziyeva adlı şəxsin guya dabaq xəstəliyinə yoluxması" ilə bağlı yayılan məlumat həqiqətə uyğun deyil:
"Qeyd edirik ki, Azərbaycanda son 30 il ərzində insanlar arasında dabaq xəstəliyi qeydə alınmayıb. Hazırda ölkə ərazisində bu xəstəliklə bağlı insanlar arasında yoluxma faktı aşkarlanmayıb".
Nazirlik vətəndaşlara müraciət edərək bildirib ki, yalnız rəsmi mənbələrin təsdiqlədiyi məlumatlara etibar edilsin.